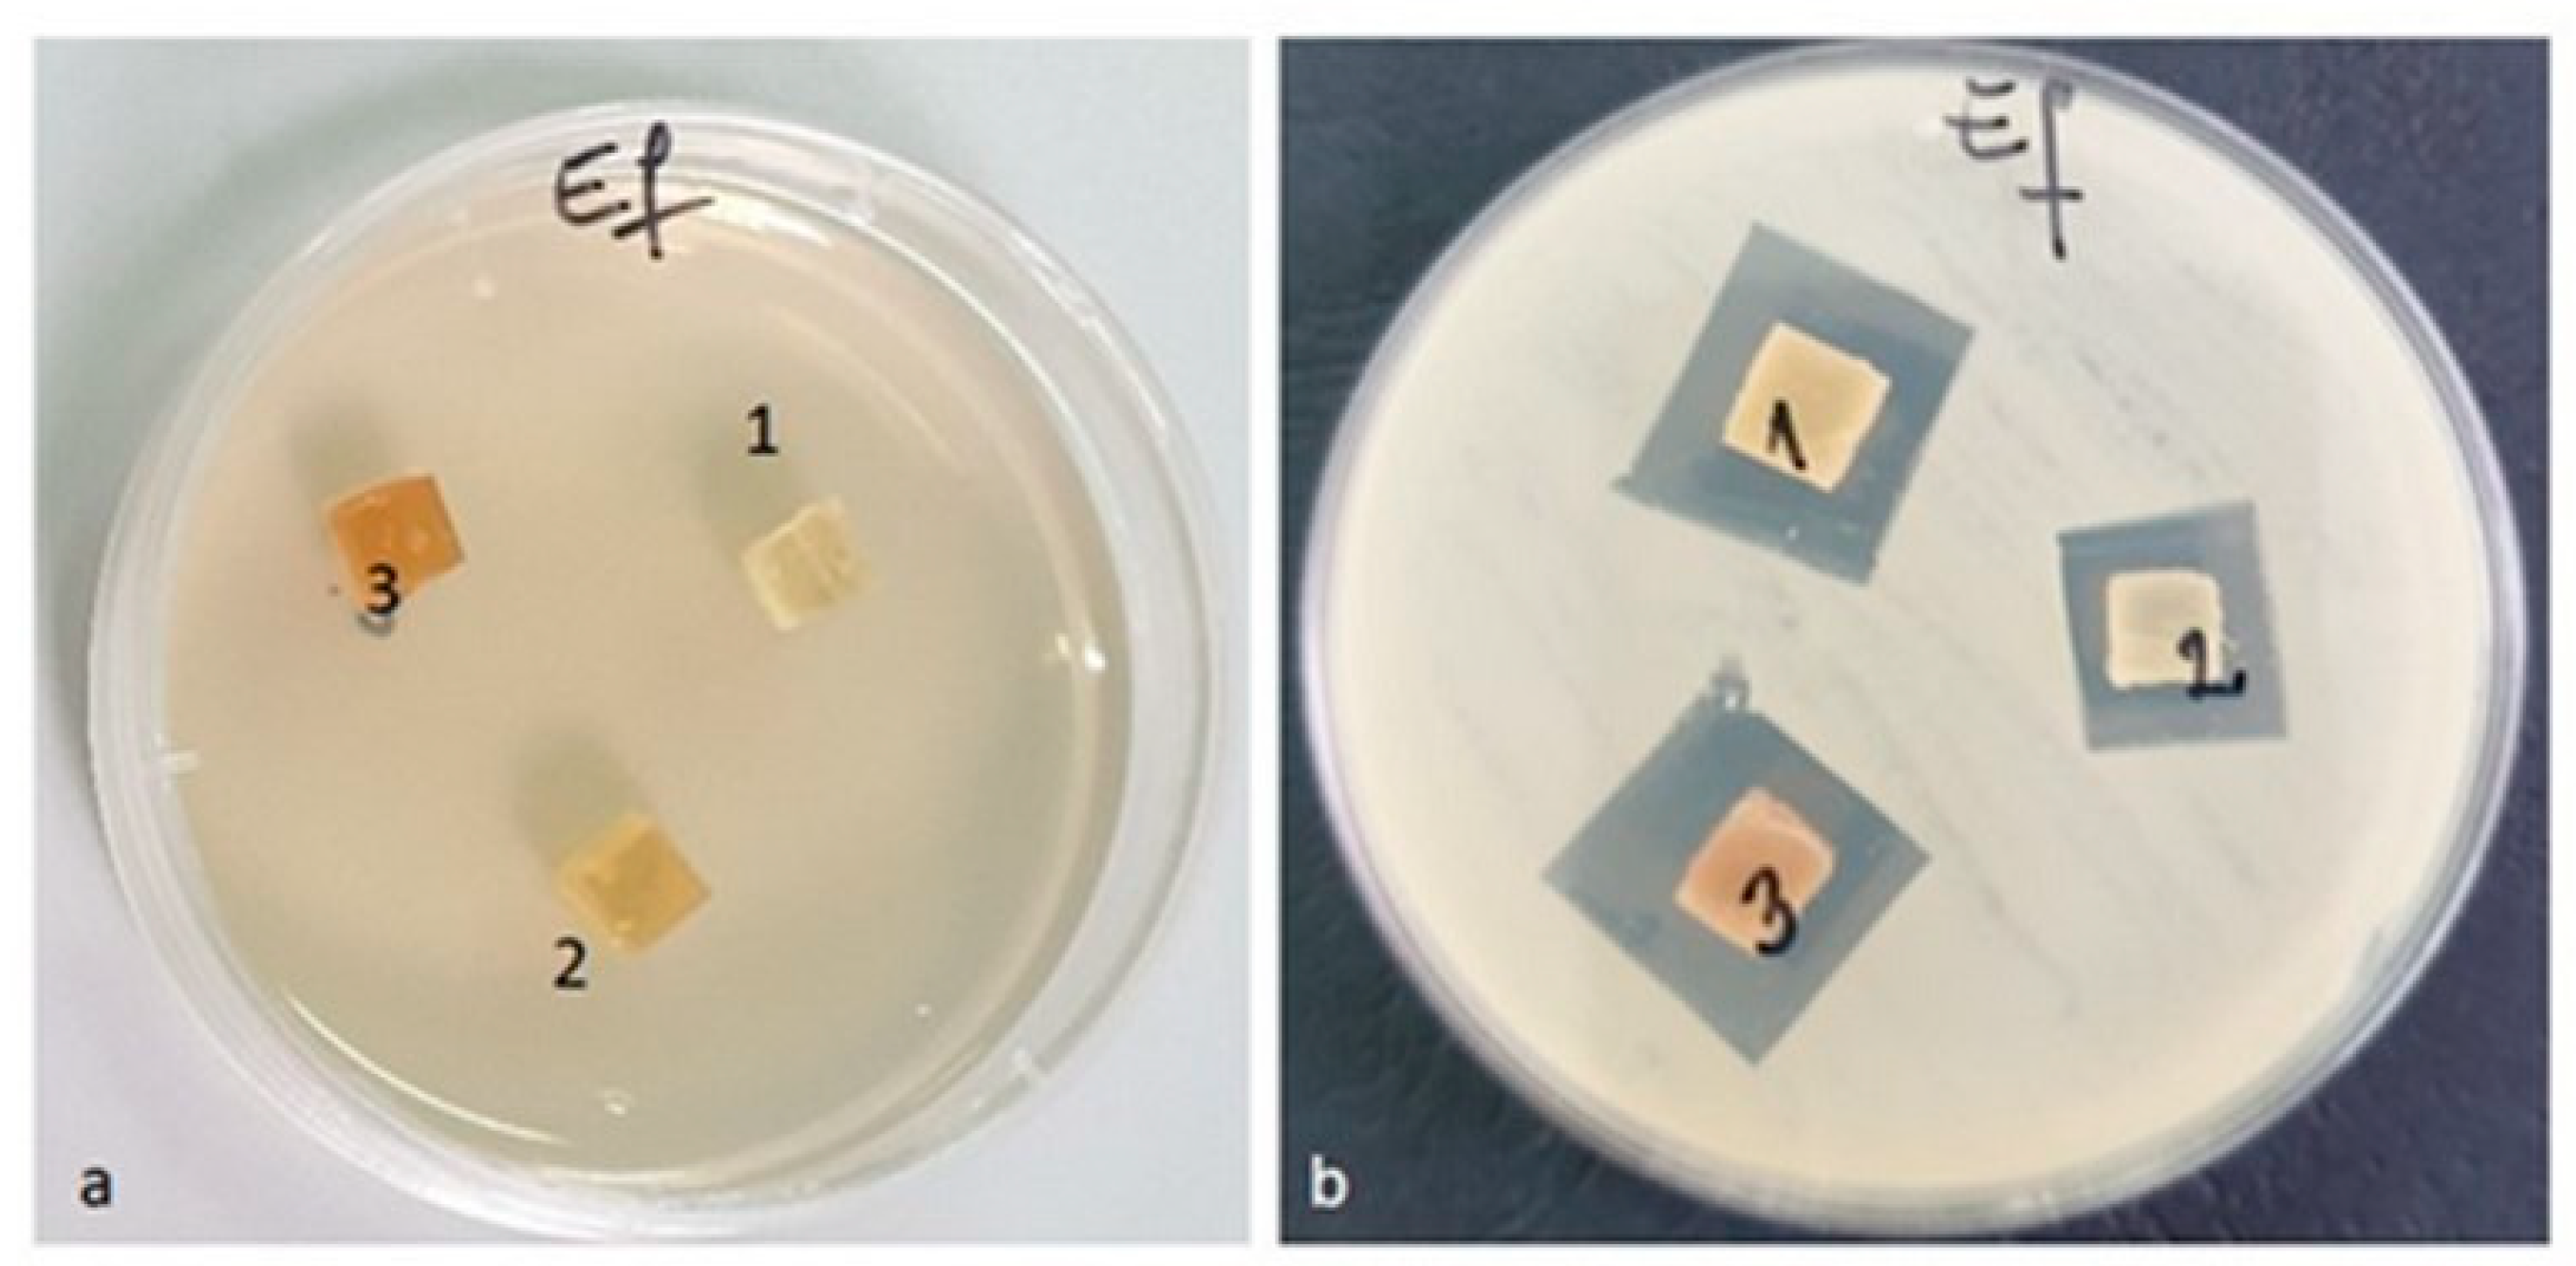
Materials 16 01415 g014
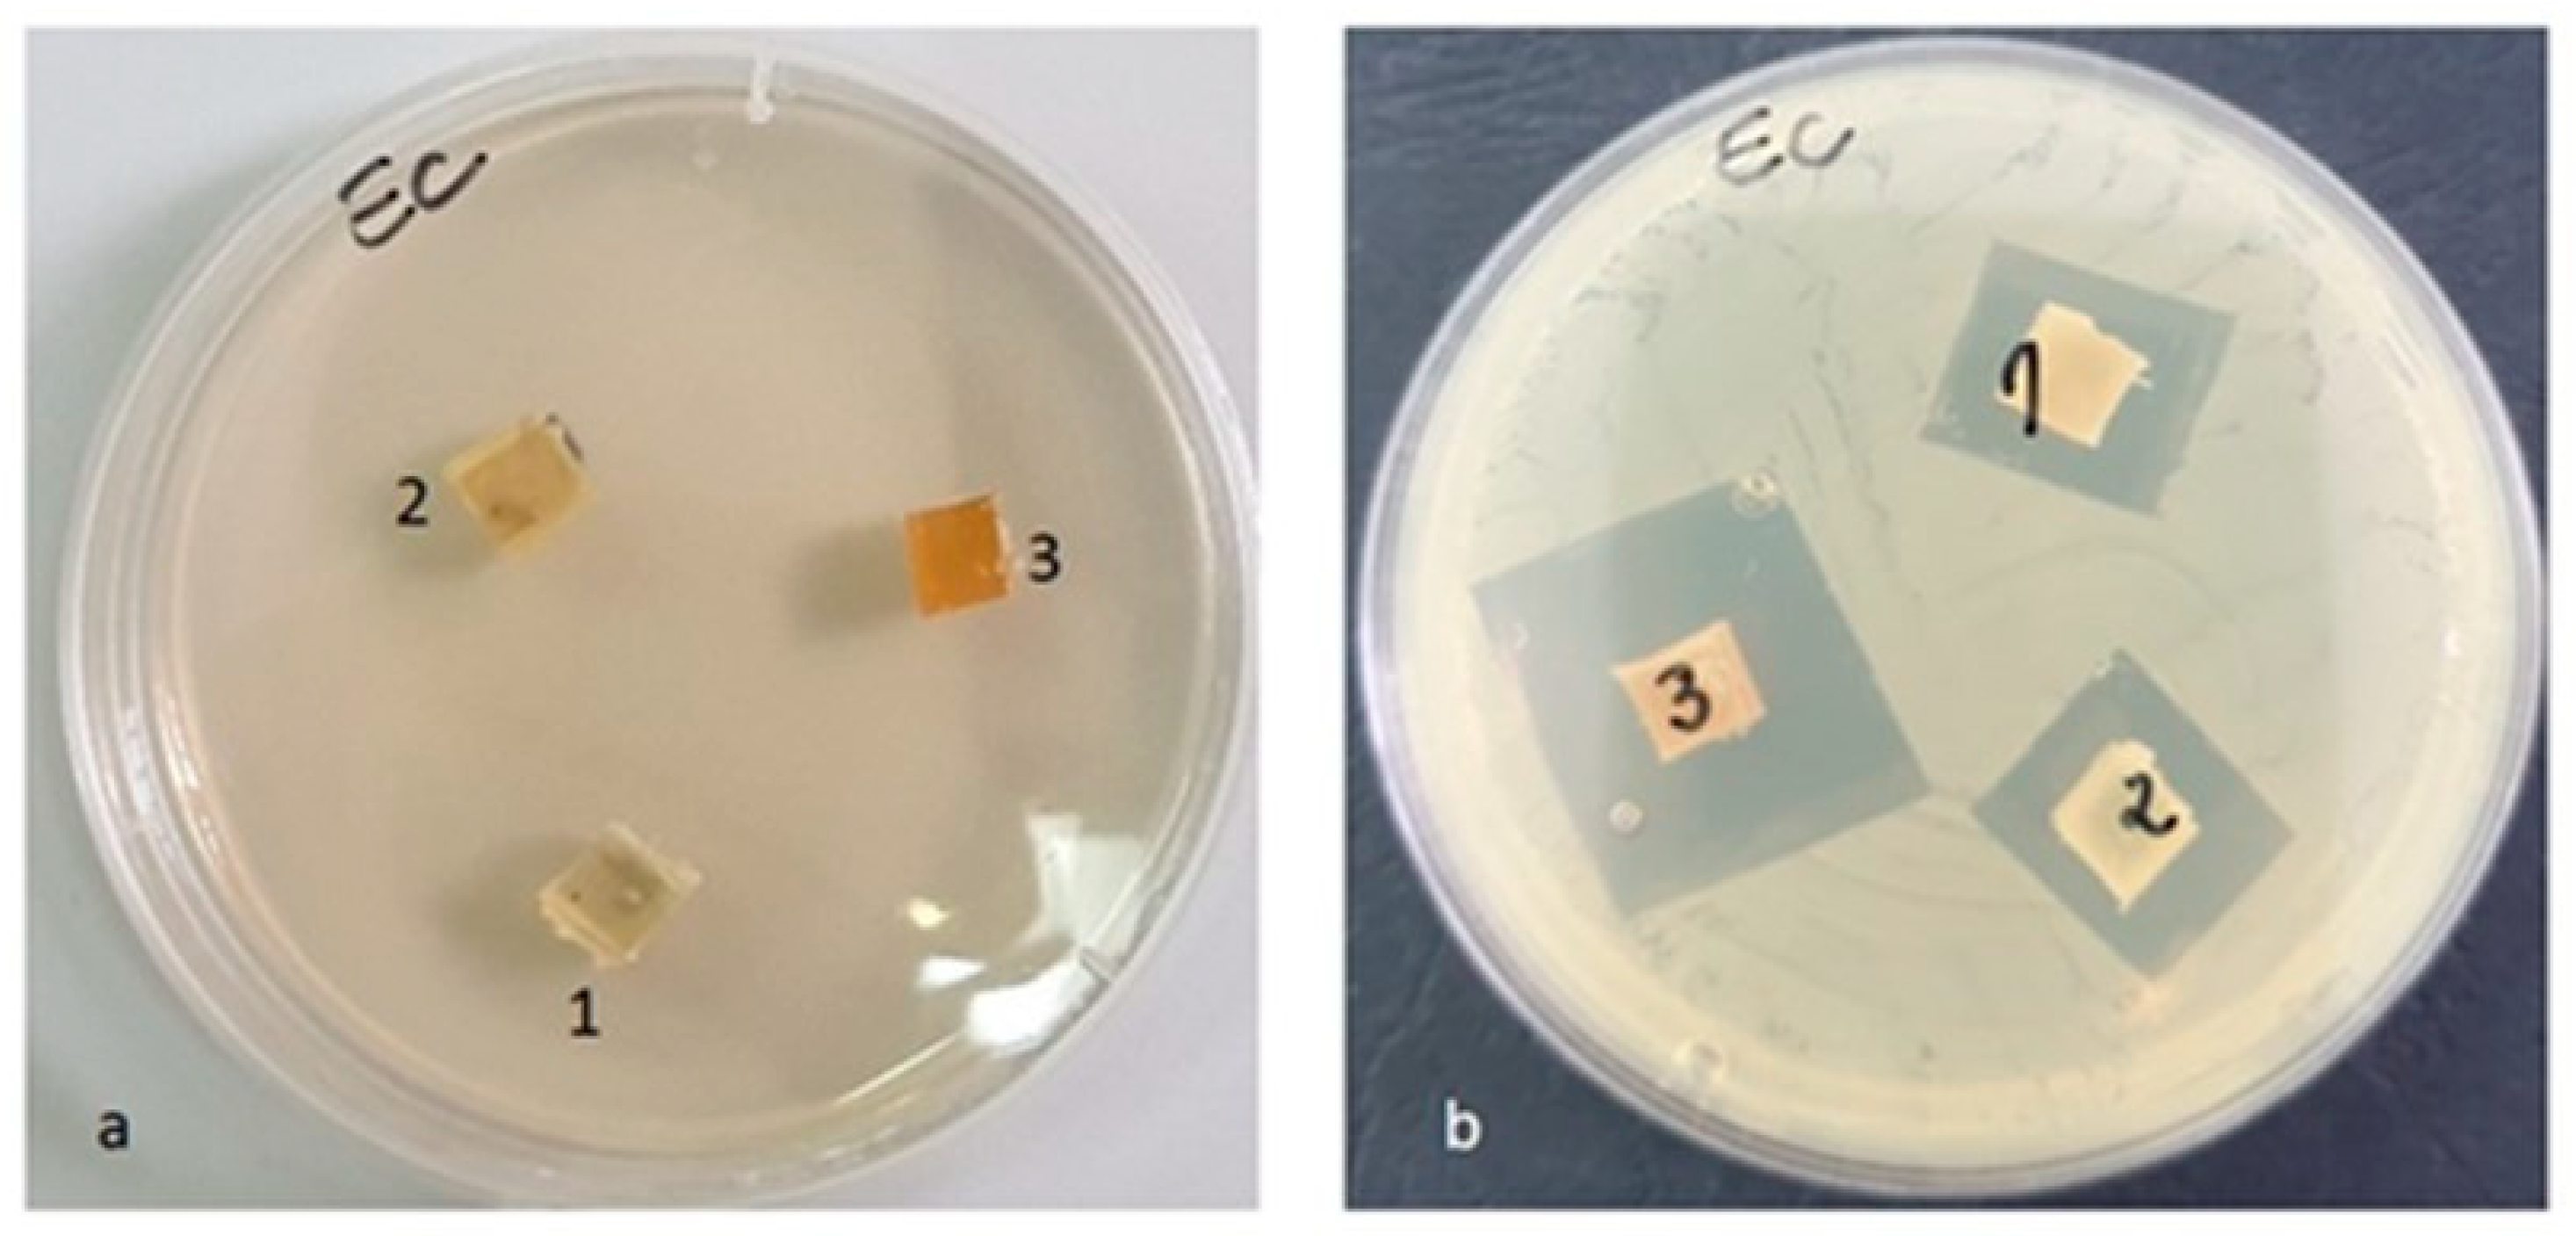
Materials 16 01415 g015
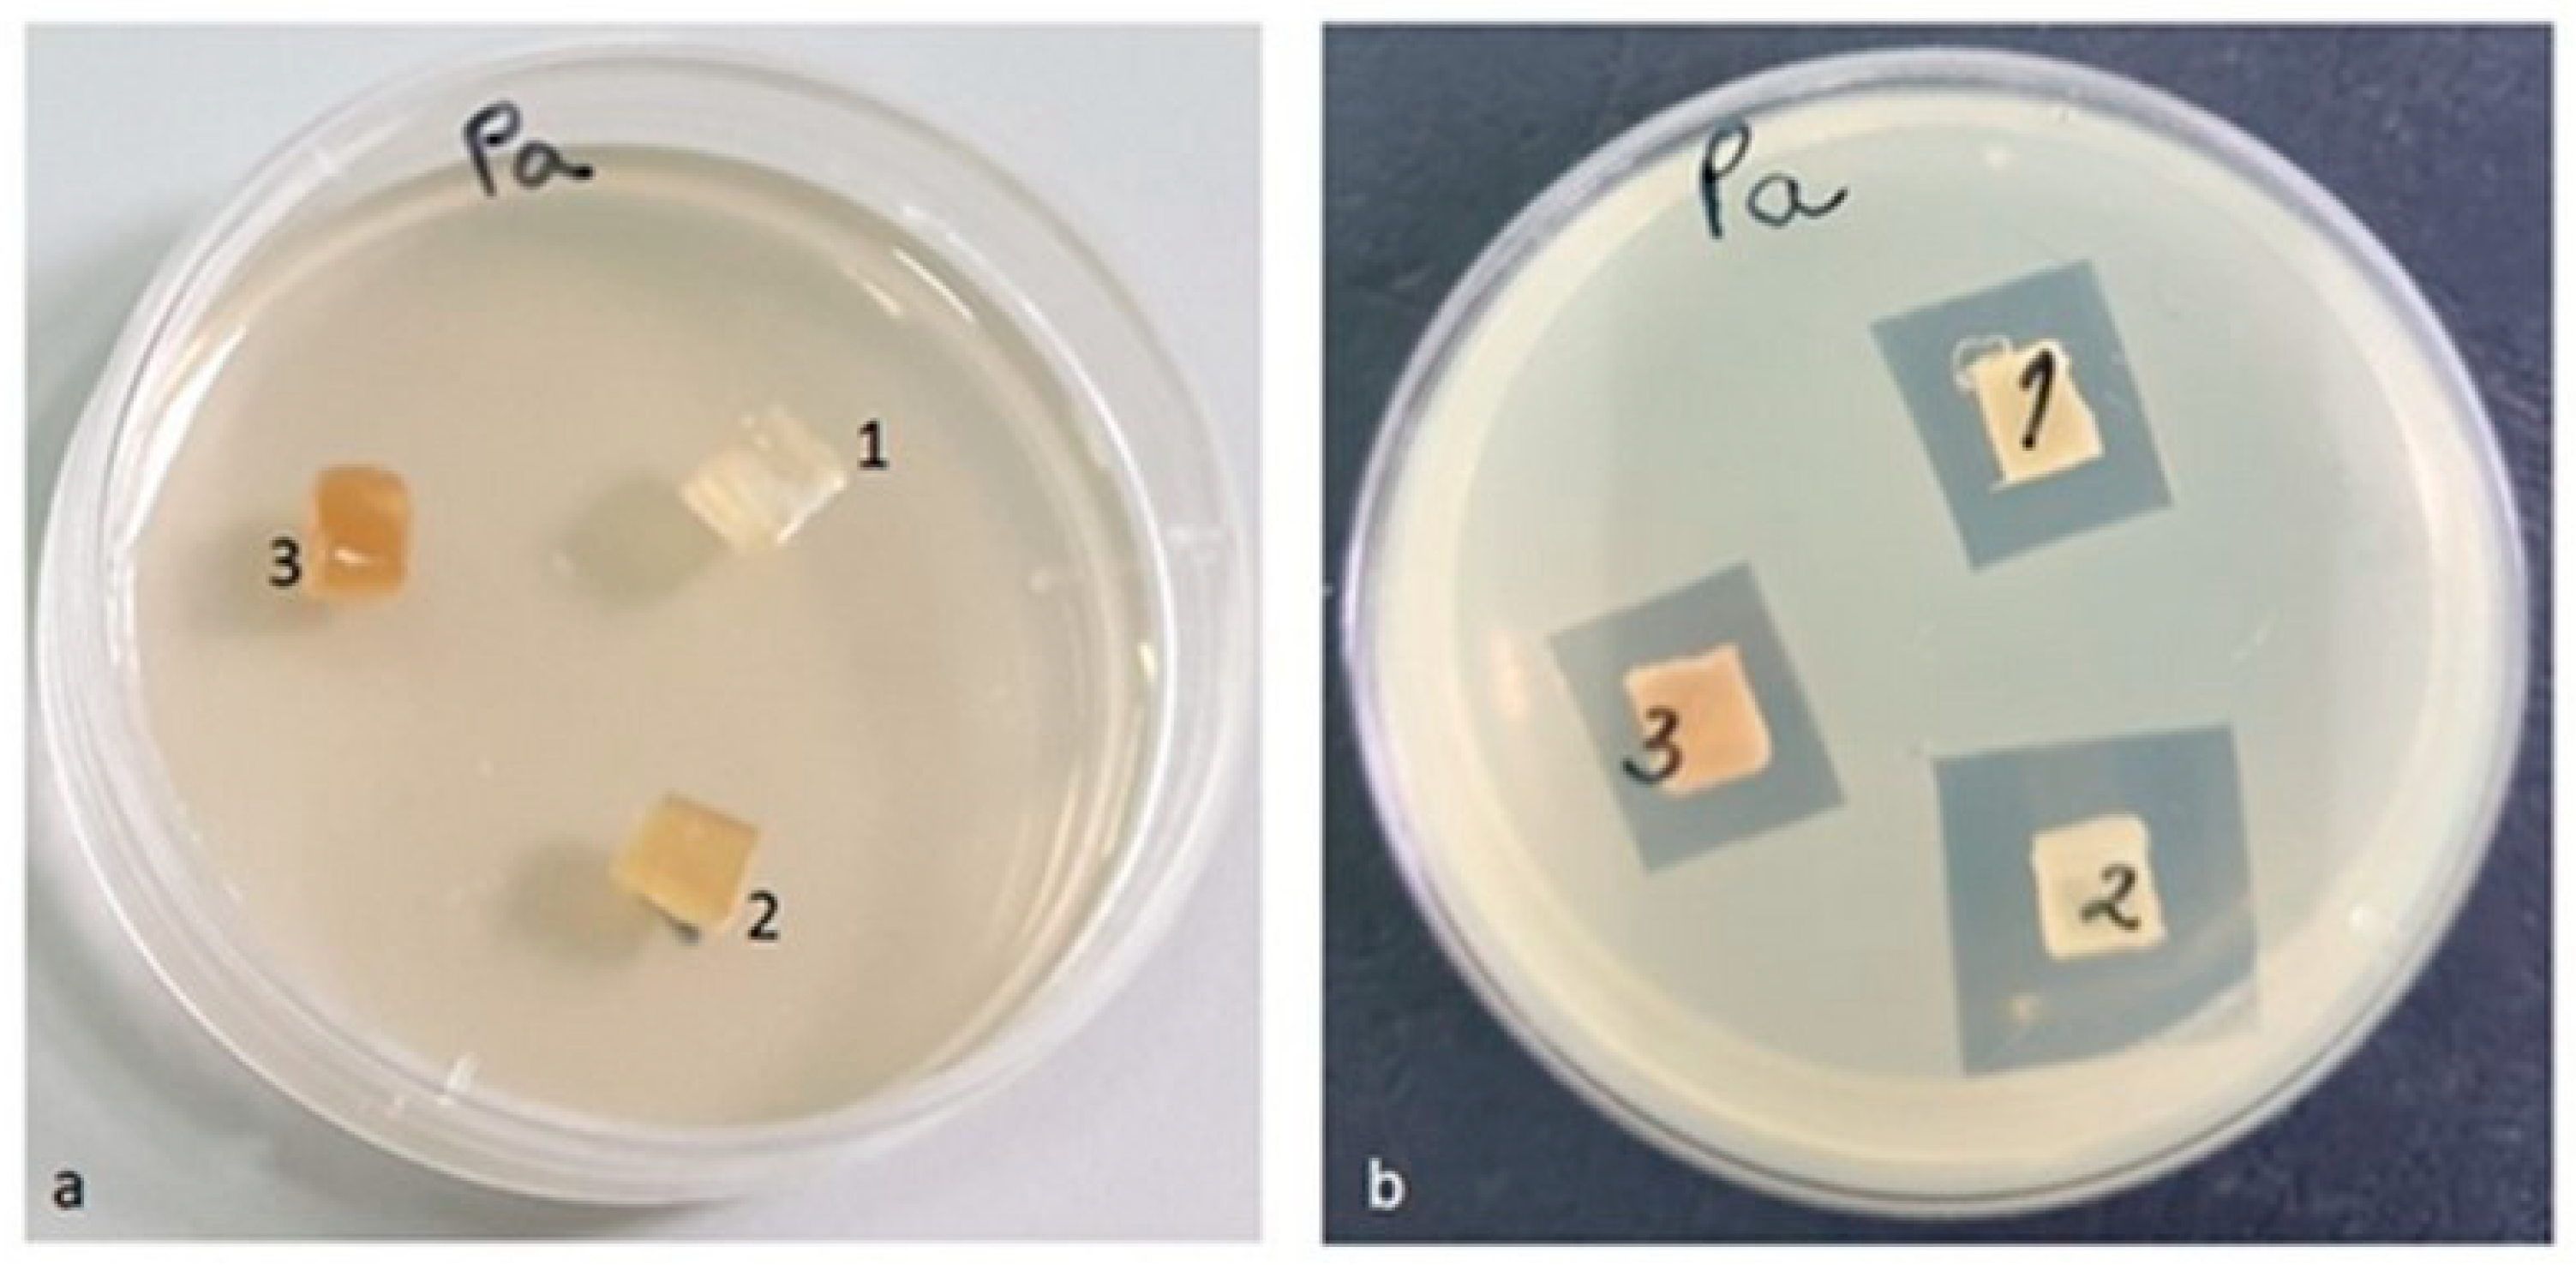
Materials 16 01415 g017

Antimicrobial Poly (Lactic Acid)/Copper Nanocomposites for Food Packaging Materials
Abstract
:1. Introduction
2. Materials and Methods
2.1. Materials
2.1.1. Obtaining of the Cu-PEG Clusters
2.1.2. Obtaining of the PLA-Based Composites
2.2. Characterization of the CuSO4-PEG Clusters
2.2.1. Scanning Electron Microscopy (SEM)
2.2.2. Fourier Transform Infrared Spectroscopy (FT-IR)
2.2.3. Ultraviolet-Visible Spectroscopy (UV-VIS)
2.3. Characterization of the PLA Cu Samples
2.3.1. Fourier Transform Infrared (FT-IR)
2.3.2. Tensile Strength Testing
2.3.3. Flexural Strength Testing
2.3.4. Differential Scanning Calorimetry (DSC)
2.3.5. Thermogravimetric Analysis
2.3.6. Absorption of the Saline Solution (%)
2.3.7. Contact Angle
2.3.8. Antimicrobial Activity
3. Results and Discussion
3.1. The Formation of Copper Particles
3.2. Characterization of the Cu-PEG Clusters
3.2.1. Scanning Electron Microscopy (SEM)
3.2.2. Fourier Transform Infrared (FT-IR)
3.2.3. Ultraviolet-Visible Spectroscopy (UV-VIS)
3.3. Characterization of the PLA–Cu Samples
3.3.1. Fourier Transform Infrared (FT-IR)
3.3.2. Tensile Strength Testing
3.3.3. Flexural Strength Testing
3.3.4. Differential Scanning Calorimetry (DSC)
3.3.5. Thermogravimetric Analysis (TGA)
3.3.6. Absorption of the Saline Solution (%)
3.3.7. Contact Angle
3.3.8. Scanning Electron Microscopy of PLA Cu Sample
3.3.9. Antimicrobial Activity
4. Conclusions
Author Contributions
Funding
Institutional Review Board Statement
Informed Consent Statement
Data Availability Statement
Acknowledgments
Conflicts of Interest
References
- Cruz, R.M.S.; Krauter, V.; Krauter, S.; Agriopoulou, S.; Weinrich, R.; Herbes, C.; Scholten, P.B.V.; Uysal-Unalan, I.; Sogut, E.; Kopacic, S.; et al. Bioplastics for Food Packaging: Environmental Impact, Trends and Regulatory Aspects. Foods 2022, 11, 3087. [Google Scholar] [CrossRef] [PubMed]
- Ncube, L.K.; Ude, A.U.; Ogunmuyiwa, E.N.; Zulkifli, R.; Beas, I.N. Environmental impact of food packaging materials: A review of contemporary development from conventional plastics to polylactic acid based materials. Materials 2020, 13, 4994. [Google Scholar] [CrossRef] [PubMed]
- Chowdhury, P.P.; Shaik, A.H.; Chakraborty, J. Preparation of Stable Sub 10 nm Copper Nanopowders Redispersible in Polar and Non-Polar Solvents. Colloids Surf. A Physicochem. Eng. Asp. 2015, 466, 189–196. [Google Scholar] [CrossRef]
- Fathima, J.B.; Pugazhendhi, A.; Oves, M.; Venis, R. Synthesis of Eco-Friendly Copper Nanoparticles for Augmentation of Catalytic Degradation of Organic Dyes. J. Mol. Liq. 2018, 260, 1–8. [Google Scholar] [CrossRef]
- Batista, R.A.; Espitia, P.J.P.; Quintans, J.D.S.S.; Freitas, M.M.; Cerqueira, M.Â.; Teixeira, J.A.; Cardoso, J.C. Hydrogel as an Alternative Structure for Food Packaging Systems. Carbohydr. Polym. 2019, 205, 106–116. [Google Scholar] [CrossRef] [PubMed]
- Mostafavi, F.S.; Zaeim, D. Agar-Based Edible Films for Food Packaging Applications—A Review. Int. J. Biol. Macromol. 2020, 159, 1165–1176. [Google Scholar] [CrossRef]
- Ahmed, I.; Lin, H.; Zou, L.; Brody, A.L.; Li, Z.; Qazi, I.M.; Pavase, T.R.; Lv, L. A Comprehensive Review on the Application of Active Packaging Technologies to Muscle Foods. Food Control 2017, 82, 163–178. [Google Scholar] [CrossRef]
- Langard, S.; Norseth, T.; Friberg, L. Handbook on the Toxicology of Metals; Elsevier: Amsterdam, The Netherlands, 1986; pp. 322–345. [Google Scholar]
- Almasi, H.; Jafarzadeh, P.; Mehryar, L. Fabrication of Novel Nanohybrids by Impregnation of CuO Nanoparticles into Bacterial Cellulose and Chitosan Nanofibers: Characterization, Antimicrobial and Release Properties. Carbohydr. Polym. 2018, 186, 273–281. [Google Scholar]
- Khalid, H.; Shamaila, S.; Zafar, N.; Shahzadi, S. Synthesis of copper nanoparticles by chemical reduction method. Sci. Int. 2015, 27, 3085–3088. [Google Scholar]
- Xiong, J.; Wang, Y.; Xue, Q.; Wu, X. Synthesis of Highly Stable Dispersions of Nanosized Copper Particles Using L-Ascorbic Acid. Green Chem. 2011, 13, 900–904. [Google Scholar] [CrossRef]
- Su, X.; Zhao, J.; Bala, H.; Zhu, Y.; Gao, Y.; Ma, S.; Wang, Z. Fast Synthesis of Stable Cubic Copper Nanocages in the Aqueous Phase. J. Phys. Chem. C 2007, 111, 14689–14693. [Google Scholar]
- Zhu, H.; Lin, Y.; Yin, Y. A Novel One-Step Chemical Method for Preparation of Copper Nanofluids. J. Colloid Interface Sci. 2004, 277, 100–103. [Google Scholar] [PubMed]
- Song, X.; Sun, S.; Zhang, W.; Yin, Z. A Method for the Synthesis of Spherical Copper Nanoparticles in the Organic Phase. J. Colloid Interface Sci. 2004, 273, 463–469. [Google Scholar] [PubMed]
- Kotelnikova, N.; Vainio, U.; Pirkkalainen, K.; Serimaa, R. Novel Approaches to Metallization of Cellulose by Reduction of Cellulose-Incorporated Copper and Nickel Ions; Wiley Online Library: Hoboken, NJ, USA, 2007; Volume 254, pp. 74–79. [Google Scholar]
- Prucek, R.; Kvítek, L.; Panáček, A.; Vančurová, L.; Soukupová, J.; Jančík, D.; Zbořil, R. Polyacrylate-Assisted Synthesis of Stable Copper Nanoparticles and Copper (I) Oxide Nanocubes with High Catalytic Efficiency. J. Mater. Chem. 2009, 19, 8463–8469. [Google Scholar]
- Gotoh, Y.; Igarashi, R.; Ohkoshi, Y.; Nagura, M.; Akamatsu, K.; Deki, S. Preparation and Structure of Copper Nanoparticle/Poly (Acrylic Acid) Composite Films. J. Mater. Chem. 2000, 10, 2548–2552. [Google Scholar] [CrossRef]
- Park, B.K.; Jeong, S.; Kim, D.; Moon, J.; Lim, S.; Kim, J.S. Synthesis and Size Control of Monodisperse Copper Nanoparticles by Polyol Method. J. Colloid Interface Sci. 2007, 311, 417–424. [Google Scholar] [CrossRef] [PubMed]
- Ostaeva, G.Y.; Selishcheva, E.; Pautov, V.; Papisov, I. Pseudotemplate Synthesis of Copper Nanoparticles in Solutions of Poly (Acrylic Acid)-Pluronic Blends. Polym. Sci. Ser. B 2008, 50, 147–149. [Google Scholar]
- Ramos, A.R.; Tapia, A.K.G.; Piñol, C.M.N.; Lantican, N.B.; del Mundo, M.L.F.; Manalo, R.D.; Herrera, M.U. Effects of Reaction Temperatures and Reactant Concentrations on the Antimicrobial Characteristics of Copper Precipitates Synthesized Using L-Ascorbic Acid as Reducing Agent. J. Sci. Adv. Mater. Devices 2019, 4, 66–71. [Google Scholar] [CrossRef]
- Shankar, S.; Rhim, J.-W. Effect of Copper Salts and Reducing Agents on Characteristics and Antimicrobial Activity of Copper Nanoparticles. Mater. Lett. 2014, 132, 307–311. [Google Scholar] [CrossRef]
- Raspolli Galletti, A.M.; Antonetti, C.; Marracci, M.; Piccinelli, F.; Tellini, B. Novel Microwave-Synthesis of Cu Nanoparticles in the Absence of Any Stabilizing Agent and Their Antibacterial and Antistatic Applications. Appl. Surf. Sci. 2013, 280, 610–618. [Google Scholar] [CrossRef]
- Sooch, B.S.; Mann, M.K. Nanoreinforced Biodegradable Gelatin Based Active Food Packaging Film for the Enhancement of Shelf Life of Tomatoes (Solanum Lycopersicum L.). Food Control 2021, 130, 108322. [Google Scholar] [CrossRef]
- Chandran, N.; Sarika, K.S.; Manikanta, B.; Nair, S.S. Structural and Optical Properties of Copper Nanoparticles Synthesized via Wet Chemical Route. AIP Conf. Proc. 2020, 2244, 70020. [Google Scholar] [CrossRef]
- Mandke, M.V.; Pathan, H.M. Electrochemical Growth of Copper Nanoparticles: Structural and Optical Properties. J. Electroanal. Chem. 2012, 686, 19–24. [Google Scholar] [CrossRef]
- Khan, A.; Rashid, A.; Younas, R.; Chong, R. A chemical reduction approach to the synthesis of copper nanoparticles. Int. Nano Lett. 2016, 6, 21–26. [Google Scholar] [CrossRef]
- Reverberi, A.P.; Salerno, M.; Lauciello, S.; Fabiano, B. Synthesis of Copper Nanoparticles in Ethylene Glycol by Chemical Reduction with Vanadium (+2) Salts. Materials 2016, 9, 809. [Google Scholar]
- Lagaron, J.; Sanchez-Garcia, M.; Gimenez, E. Thermoplastic Nanobiocomposites for Rigid and Flexible Food Packaging Applications. In Environmentally Compatible Food Packaging; Elsevier: Amsterdam, The Netherlands, 2008; pp. 63–89. [Google Scholar]
- Ortenzi, M.A.; Gazzotti, S.; Marcos, B.; Antenucci, S.; Camazzola, S.; Piergiovanni, L.; Farina, H.; Di Silvestro, G.; Verotta, L. Synthesis of Polylactic Acid Initiated through Biobased Antioxidants: Towards Intrinsically Active Food Packaging. Polymers 2020, 12, 1183. [Google Scholar] [CrossRef]
- Muna, L.K.; Ramaswami Sachidanandan, E.R.; Veeramai, S. Greener Synthesized Copper Nanoparticles Incorporated in Polyethylene Glycol/Polyvinyl Alcohol Nanocomposite for Food Package Applications. J. Nanostructures 2022, 12, 224–234. [Google Scholar]
- Javed, R.; Ahmed, M.; ul Haq, I.; Nisa, S.; Zia, M. PVP and PEG Doped CuO Nanoparticles Are More Biologically Active: Antibacterial, Antioxidant, Antidiabetic and Cytotoxic Perspective. Mater. Sci. Eng. C 2017, 79, 108–115. [Google Scholar]
- Mulla, M.Z.; Rahman, M.R.T.; Marcos, B.; Tiwari, B.; Pathania, S. Poly Lactic Acid (PLA) Nano-composites: Effect of Inorganic Nanoparticles Reinforcement on Its Performance and Food Packaging Applications. Molecules 2021, 26, 1967. [Google Scholar] [CrossRef]
- Ortenzi, M.A.; Basilissi, L.; Farina, H.; Di Silvestro, G.; Piergiovanni, L.; Mascheroni, E. Evaluation of Crystallinity and Gas Barrier Properties of Films Obtained from PLA Nanocomposites Synthesized via “In Situ” Polymerization of l-Lactide with Silane-Modified Nanosilica and Montmorillonite. Eur. Polym. J. 2015, 66, 478–491. [Google Scholar] [CrossRef]
- Rahman, M.R.; Hui, J.L.C.; Bin Hamdan, S. Nanoclay Dispersed Phenol Formaldehyde/Fumed Silica Nanocomposites: Effect of Diverse Clays on Physicomechanical and Thermal Properties. In Silica and Clay Dispersed Polymer Nanocomposites; Woodhead Publishing: Cambridge, UK, 2018; pp. 59–70. [Google Scholar]
- Atlas, R.M. Handbook of Microbiological Media; CRC Press: Boca Raton, FL, USA, 2004; ISBN 0-429-12903-3. [Google Scholar]
- Carpa, R.; Drăgan-Bularda, M.; Muntean, V. Microbiologie Generală: Lucrări Practice; Presa Universitară Clujeană: Cluj-Napoca, Romania, 2014; ISBN 973-595-694-2. [Google Scholar]
- Liu, Q.; Yasunami, T.; Kuruda, K.; Okido, M. Preparation of Cu Nanoparticles with Ascorbic Acid by Aqueous Solution Reduction Method. Trans. Nonferrous Met. Soc. China 2012, 22, 2198–2203. [Google Scholar] [CrossRef]
- Dang, T.M.D.; Le, T.T.T.; Fribourg-Blanc, E.; Dang, M.C. Synthesis and Optical Proper-ties of Copper Nanoparticles Prepared by a Chemical Reduction Method. Adv. Nat. Sci. Nanosci. Nanotechnol. 2011, 2, 15009. [Google Scholar] [CrossRef]
- Shameli, K.; Bin Ahmad, M.; Jazayeri, S.D.; Sedaghat, S.; Shabanzadeh, P.; Jahangirian, H.; Mahdavi, M.; Abdollahi, Y. Synthesis and Characterization of Polyethylene Glycol Mediated Silver Nanoparticles by the Green Method. Int. J. Mol. Sci. 2012, 13, 6639–6650. [Google Scholar] [CrossRef]
- Dinça, C.Ö.; Günerb, A. Solid-State Characterization of Poly (Ethylene Glycol) Samples Prepared by Solvent Cast. Bulg. Chem. Commun. 2017, 15, 15–20. [Google Scholar]
- Wang, F.; Ma, C.M.; Wu, W. Kinetic Parameters of Thermal Degradation of Polyethylene Glycol-toughened Novolac-type Phenolic Resin. J. Appl. Polym. Sci. 2001, 80, 188–196. [Google Scholar]
- Sarı, A. Composites of Polyethylene Glycol (PEG600) with Gypsum and Natural Clay as New Kinds of Building PCMs for Low Temperature-Thermal Energy Storage. Energy Build. 2014, 69, 184–192. [Google Scholar] [CrossRef]
- Shikha, J.; Ankita, J.; Kachhawah, P.; Devra, V. Synthesis and Size Control of Copper Nanoparticles and Their Catalytic Application. Trans. Nonferrous Met. Soc. China 2015, 25, 3995–4000. [Google Scholar]
- Sportelli, M.C.; Izzi, M.; Volpe, A.; Lacivita, V.; Clemente, M.; Di Franco, C.; Conte, A.; Del Nobile, M.A.; Ancona, A.; Cioffi, N. A New Nanocomposite Based on LASiS-Generated CuNPs as a Preservation System for Fruit Salads. Food Packag. Shelf Life 2019, 22, 100422. [Google Scholar] [CrossRef]
- Zhu, H.; Zhang, C.; Yin, Y. Rapid Synthesis of Copper Nanoparticles by Sodium Hypophosphite Reduction in Ethylene Glycol under Microwave Irradiation. J. Cryst. Growth 2004, 270, 722–728. [Google Scholar] [CrossRef]
- Södergård, A.; Stolt, M. Properties of Lactic Acid Based Polymers and Their Correlation with Composition. Prog. Polym. Sci. 2002, 27, 1123–1163. [Google Scholar]
- Sarasini, F.; Luzi, F.; Dominici, F.; Maffei, G.; Iannone, A.; Zuorro, A.; Lavecchia, R.; Torre, L.; Carbonell-Verdu, A.; Balart, R.; et al. Effect of Different Compatibilizers on Sustainable Compo-sites Based on a PHBV/PBAT Matrix Filled with Coffee Silverskin. Polymers 2018, 10, 1256. [Google Scholar] [PubMed]
- Tertyshnaya, Y.V.; Karpova, S.G.; Podzorova, M.V.; Khvatov, A.V.; Moskovskiy, M.N. Thermal Properties and Dynamic Characteristics of Electrospun Polylactide/Natural Rubber Fibers dur-ing Disintegration in Soil. Polymers 2022, 14, 1058. [Google Scholar]
- Mastalygina, E.E.; Olkhov, A.A.; Vorontsov, N.V.; Kiselev, N.V.; Khaidarov, T.B.; Khaydarov, B.B.; Kolesnikov, E.A.; Burmistrov, I.N. Influence of Copper-Based Fillers on Structural and Me-chanical Properties of Polylactic Acid Composites. J. Compos. Sci. 2022, 6, 386. [Google Scholar] [CrossRef]
- Liu, W.; Wu, X.; Chen, X.; Liu, S.; Zhang, C. Flexibly Controlling the Polycrystallinity and Improving the Foaming Behavior of Polylactic Acid via Three Strategies. ACS Omega 2022, 7, 6248–6260. [Google Scholar]
- Rosli, N.A.; Ahmad, I.; Anuar, F.H.; Abdullah, I. Effectiveness of cellulosic Agave angustifolia fibres on the performance of compatibilised poly(lactic acid)-natural rubber blends. Cellulose 2019, 26, 3205–3218. [Google Scholar] [CrossRef]
- Rosli, N.A.; Karamanlioglu, M.; Kargarzadeh, H.; Ahmad, I. Comprehensive exploration of natural degradation of poly (lactic acid) blends in various degradation media: A review. Int. J. Biol. Macromol. 2021, 187, 732–741. [Google Scholar] [CrossRef]
- Pulgarin, H.L.C.; Caicedo, C.; López, E.F. Effect of surfactant content on rheological, thermal, morphological and surface properties of thermoplastic starch (TPS) and polylactic acid (PLA) blends. Heliyon 2022, 8, e10833. [Google Scholar] [CrossRef]
- Hona, S.; Dangol, R.; Ghatane, J.; Giri, D.; Pradhananga, R.R. Antimicrobial Effect of Copper Nanoparticles Synthesized by Chemical Method. Int. J. Appl. Sci. Biotechnol. 2019, 7, 421–428. [Google Scholar] [CrossRef]
- Longano, D.; Ditaranto, N.; Cioffi, N.; Di Niso, F.; Sibillano, T.; Ancona, A.; Conte, A.; Del Nobile, M.A.; Sabbatini, L.; Torsi, L. Analytical Characterization of Laser-Generated Copper Nanoparticles for Antibacterial Composite Food Packaging. Anal. Bioanal. Chem. 2012, 403, 1179–1186. [Google Scholar] [CrossRef]
- Tamayo, L.; Azócar, M.; Kogan, M.; Riveros, A.; Páez, M. Copper-Polymer Nanocomposites: An Excellent and Cost-Effective Biocide for Use on Antibacterial Surfaces. Mater. Sci. Eng. C 2016, 69, 1391–1409. [Google Scholar] [CrossRef]

| Sample No. | Polylactic Acid [wt%] | Proviplast 2624 [wt%] | PEG 600 + CuSO4 [wt%] |
|---|---|---|---|
| PLA Cu1 | 84 | 15 | 1 |
| PLA Cu2 | 83 | 15 | 2 |
| PLA Cu3 | 82 | 15 | 3 |
| PLACu1 | PLACu2 | PLACu3 | Attribution |
|---|---|---|---|
| 870 | 868 | 868 | C–C stretching |
| 1043 | 1043 | 1043 | C–CH3 stretching |
| 1180 1130 1082 | 1180 1128 1085 | 1182 1128 1079 | C–O–C asymmetrical stretching |
| 1265 | 1265 | 1267 | C=O bending |
| 1383 1359 | 1383 1359 | 1383 1359 | CH δ (asymmetrical and symmetrical) |
| 1359 | |||
| 1454 | 1454 | 1452 | CH3 δ asymmetrical |
| 1749 | 1749 | 1749 | C=O stretching |
| Samples Code | Tensile Strength (MPa) | The Highest Reached Force [N] | Breaking Strength [N] | Young Modulus [MPa] | Breaking Elongation [mm] | Breaking Stress [MPa] |
|---|---|---|---|---|---|---|
| PLA Cu1 | 20.6358 ± 2.03341 | 224.2592 ± 15.92412 | 44.8518 ± 0.54774 | 1322.8194 ± 663.43933 | 10.3244 ± 1.07951 | 4.1271 ± 0.49338 |
| PLA Cu2 | 16.8036 ± 0.49944 | 116.1344 ± 9.11474 | 25.2663 ± 0.46761 | 904.5661 ± 42.74934 | 9.8474 ± 1.35432 | 6.8084 ± 0.48921 |
| PLA Cu3 | 12.9715 ± 1.67583 | 109.5749 ± 5.68169 | 22.8479 ± 1.90622 | 874.1094 ± 75.00176 | 5.79814 ± 0.47594 | 10.4781 ± 0.5244 |
| p | 0.00199 | 2.61422 × 10−5 | 6.0359 × 10−7 | 0.97324 | 0.00749 | 2.03095 × 10−5 |
| Samples Code | Maximum Load [N] | Young Modulus [MPa] | Bending Stiffness [Nm2] | Maximum Bending Stress at Maximum Load [MPa] | Elongation [mm] |
|---|---|---|---|---|---|
| PLA Cu1 | 104.7791 ± 2.82514 | 874.9952 ± 56.19848 | 0.032 ± 0.003 | 45.7740 ± 4.30885 | 5.5509 ± 0.50416 |
| PLA Cu2 | 68.6247 ± 1.76737 | 722.0915 ± 30.34548 | 0.022 ± 0.00569 | 29.5459 ± 3.56033 | 5.828 ± 0.54864 |
| PLA Cu3 | 68.4348 ± 1.00393 | 420.3860 ± 15.23471 | 0.012 ± 0.002 | 24.8904 ± 2.08914 | 7.6838 ± 0.23053 |
| p | 9.8591 × 10−7 | 2.13035 × 10−5 | 0.00221 | 7.4621 × 10−4 | 0.00156 |
| Sample | Amount [mg] | DSC | Process | |
|---|---|---|---|---|
| Temperature Range [°C] | The Phase Transformation Temperatures [°C] | |||
| PLA Cu1 | 10.466 | 25–100 | 83.41 | exothermic |
| 100–200 | Onset~136 149.99 | endotherm | ||
| PLA Cu2 | 10.430 | 25–110 | 81.59 | exothermic |
| 110–200 | Onset 138.28 149.14 | endotherm | ||
| PLA Cu3 | 11.259 | 25–90 | 70.72 | exothermic |
| 90–200 | Onset 125.88 144.93 | endotherm | ||
| Sample | Temperature for Mass Loss of 15% by Weight, °C |
|---|---|
| PLA-Cu1 | 287 |
| PLA-Cu2 | 273 |
| PLA-Cu3 | 271 |
| Sample | Immersion Time | ||||
|---|---|---|---|---|---|
| 1 Day | 4 Days | 7 Days | 14 Days | p | |
| PLA Cu1 | 0.24824 ± 0.02446 | 0.37502 ± 0.04044 | 0.39234 ± 0.01594 | 0.37594 ± 0.00909 | 0.01388 |
| PLA Cu2 | 1.76949 ± 2.0064 | 0.53089 ± 0.00182 | 0.59365 ± 0.01568 | 0.62693 ± 0.00283 | 0.59862 |
| PLA Cu3 | 0.49399 ± 0.17411 | 0.43393 ± 0.04571 | 0.5106 ± 0.05717 | 0.42293 ± 0.0163 | 0.74927 |
| Sample Numbering/Sample Code | 1 | 2 | 3 |
|---|---|---|---|
| PLA Cu2 | PLA Cu1 | PLA Cu3 | |
| Bacterial strain | |||
| Enterococcus faecalis ATCC 29212 | 18 | 14 | 17 |
| Escherichia coli ATCC 25922 | 16 | 15 | 22 |
| Staphylococcus aureus ATCC 25923 | 20 | 14 | 22 |
| Pseudomonas aeruginosa ATCC 27853 | 15 | 20 | 16 |
Disclaimer/Publisher’s Note: The statements, opinions and data contained in all publications are solely those of the individual author(s) and contributor(s) and not of MDPI and/or the editor(s). MDPI and/or the editor(s) disclaim responsibility for any injury to people or property resulting from any ideas, methods, instructions or products referred to in the content. |
© 2023 by the authors. Licensee MDPI, Basel, Switzerland. This article is an open access article distributed under the terms and conditions of the Creative Commons Attribution (CC BY) license (https://creativecommons.org/licenses/by/4.0/).
Share and Cite
Popescu, V.; Prodan, D.; Cuc, S.; Saroşi, C.; Furtos, G.; Moldovan, A.; Carpa, R.; Bomboş, D. Antimicrobial Poly (Lactic Acid)/Copper Nanocomposites for Food Packaging Materials. Materials 2023, 16, 1415. https://doi.org/10.3390/ma16041415
Popescu V, Prodan D, Cuc S, Saroşi C, Furtos G, Moldovan A, Carpa R, Bomboş D. Antimicrobial Poly (Lactic Acid)/Copper Nanocomposites for Food Packaging Materials. Materials. 2023; 16(4):1415. https://doi.org/10.3390/ma16041415
Chicago/Turabian StylePopescu, Violeta, Doina Prodan, Stanca Cuc, Codruţa Saroşi, Gabriel Furtos, Andrei Moldovan, Rahela Carpa, and Dorin Bomboş. 2023. "Antimicrobial Poly (Lactic Acid)/Copper Nanocomposites for Food Packaging Materials" Materials 16, no. 4: 1415. https://doi.org/10.3390/ma16041415
APA StylePopescu, V., Prodan, D., Cuc, S., Saroşi, C., Furtos, G., Moldovan, A., Carpa, R., & Bomboş, D. (2023). Antimicrobial Poly (Lactic Acid)/Copper Nanocomposites for Food Packaging Materials. Materials, 16(4), 1415. https://doi.org/10.3390/ma16041415

